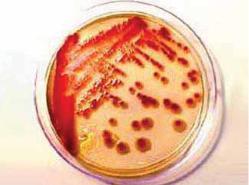

– = 1 $% > . D % > H2S. $ #$* > .
Proteus $>% % : P. mirabilis, P. myxofaciens, P. penneri, P. vulgaris ( # + ).
Proteus > 6 % ! < # %- < # % < ' < ( # ! , P. myxofaciens 6 %6$# # ), # % , % < < $>? <-% < <. = $ %$ > -! % ? < # +, ' % # % # ' # ' ! #$ < % < ! 6$* . G #-! %$, ' +6 < – # * «- >», , !$, !$> , ! # .
Providencia $ Proteus, - $ < ! % $% ( # * * H2S, - ! * $> ! , * $% ! $ - ! – !$* , $, < , $ .), ' $ -#$'$ ! $ $ + $* + .
Providencia – # ! # ' (# < ) #$% ! ! 0,6–0,8 1,5–2,5 ! !.
K !# + # ! ! $ + Providencia – 37 º .$> $ $> ! $. D > $ ( $>% ! P. heimbachae), % > #$'-$* > > !$! ! $* > G – =- 1 . $ #$* > . > $ - -$, ' $. D ?$> $ $* ! # . $> , #$ + , ' ? + 1 ! > !$.
Providencia # : P. alcalifaciens ( # + ),
P. heimbachae, P. rettgeri, P. rustigianii, P. stuartii.
25 % $ + P. stuartii 40 % 6 !! P. rettgeri ! * « ! ». $, % %$*$*6 %$ 6 !! # > #$ # !# 30 º $ # ' #$ (1,3 %). $ -# + < #$! < ( -* , # ), $% < % < - .
= + # + – %$ ( +) #- . & $> $+ # , ! % # <